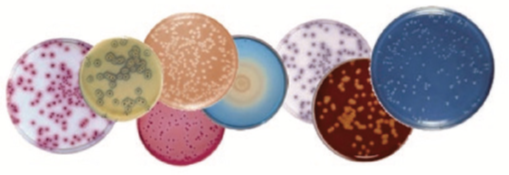
image.png

微信扫一扫
关注公众号
活体微生物菌株干燥保存板13788987962
询价
产品分类
- 酶及底物 (520)
- 免疫学 (3087)
- 标准品/对照品 (536)
- 生物制药与疫苗 (604)
- 分离纯化 (37)
- 生化试剂 (28748)
- 分子生物学 (21)
- WAKO (13608)
- Jackson ImmunoResearch (2012)
- Ludger 糖链分析 (87)
- Lumiprobe活性染料 (3)
- abcam (39100)
- Merck-Sigma (44401)
- MP Bio (11006)
- 试剂 (9706)
- 健康原料 (24)
- 新型材料 (345)
- 仪器分析 (1025)
- 合作品牌 (44464)
- Aalto
- AAT Bioquest
- AbD
- Active Motif
- Advanced Targeting Systems
- Ambion
- AnaSpec
- AssayDesign
- Avanti
- Bangs Laboratories
- BioPorto
- BioSource
- bioworld
- cayman
- Chemicon
- Clontech
- CST
- DiFco
- Epigentek
- hampton
- Himedia
- Hyclone
- ldmsapp
- Innova Biosciences
- Invent
- J.T.BAKER
- KPL
- lifespan
- MRC
- Phytotech
- Pierce
- Prozyme
- Qiagen
- R&D
- Roche
- Santa Cruz
- Vector
- Worthington
- 其他分类 (9)
服务保证
西宝风采
公司新闻
微生物检测培养基 - 应用于微生物培养、发酵、生物制药生产
发布时间:2023-12-12 08:58 | 点击次数:292
 微生物检测培养基
微生物检测培养基
应用于微生物培养、发酵、生物制药生产
Solabia Biokar Diagnostics是法国Solabia集团下负责研发和生产微生物检测培养基和培养基质的微生物部门,可提供约300种的粉末培养基、液体培养基、培养基质、补充剂、检测试剂盒等沙门氏菌、李斯特菌、假单胞菌、大肠杆菌、乳酸菌相关的产品。
◆特点
● 部分产品已获得AFNOR认证(法国标准协会;替代ISO)
沙门氏菌、李斯特菌、蜡状芽孢杆菌、假单胞菌、葡萄球菌、大肠杆菌等
● 多种符合ISO标准并且应用于食品、水和环境分析等微生物检测的培养基可供选择。
◆ 产品列表(乳酸菌用)
|
产品编号
|
厂家编号
|
产品名称
|
产品概要
|
包装
|
|
551-40101
|
BK070GC
|
MRS Broth
|
可用于食品中乳酸菌(Lactobacillus)的细菌增殖和菌数测定。
|
5 kg
|
|
556-36925
|
BK070HA
|
500 g
|


















